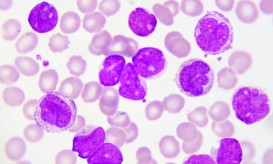
λευχαιμία

Λέμφωμα: Προσοχή στα συμπτώματα του πιο ύπουλου καρκίνου
Λέμφωμα είναι μια μορφή καρκίνου που επηρεάζει το ανοσοποιητικό σύστημα. Ειδικότερα, είναι ένας καρκίνος των κυττάρων του ανοσοποιητικού συστήματος...

Λέμφωμα είναι μια μορφή καρκίνου που επηρεάζει το ανοσοποιητικό σύστημα. Ειδικότερα, είναι ένας καρκίνος των κυττάρων του ανοσοποιητικού συστήματος...

Λέμφωμα είναι ένας τύπος καρκίνου που χτυπάει τα κύτταρα του ανοσοποιητικού συστήματος, που ονομάζονται λεμφοκύτταρα.

Το λέμφωμα είναι σχετικά εύκολο να εντοπιστεί. Ωστόσο, συχνά διαφεύγει της προσοχής μας στα πρώιμα στάδιά του. Αυτό συμβαίνει...

Σε αυτό το άρθρο, εξετάζουμε διεξοδικά τις ομοιότητες και τις διαφορές μεταξύ της λευχαιμίας και του λεμφώματος.
Η Novartis ανακοίνωσε αναλύσεις με μεγαλύτερη χρονική διάρκεια των μελετών ELIANA και JULIET, των βασικών κλινικών μελετών του Tisagenlecleucel...

Ελπίδες για μακρά και καλής ποιότητας ζωής προσφέρουν οι νέες θεραπείες σε ασθενείς με λέμφωμα που είτε είναι εξ...

Η ανοσοθεραπεία δίνει ελπίδα σε ασθενείς με δύσκολα αντιμετωπίσιμες μορφές λεμφώματος και λευχαιμίας.

Η πιο συχνή μορφή καρκίνου στο αίμα είναι το λέμφωμα, ενώ δεύτερη σε συχνότητα είναι η λευχαιμία. Ωστόσο και...

Η λευχαιμία και το λέμφωμα έχουν διάφορα συμπτώματα, που όμως είναι μη ειδικά, δηλαδή μπορεί να οφείλονται και σε...

Σύμφωνα με ανακοίνωση του Simon Stevens, διευθύνοντα συμβούλου του Εθνικού Συστήματος Υγείας (NHS) της Αγγλίας, οι ενήλικες ασθενείς στην...

Η Kite, θυγατρική εταιρεία της Gilead, ανακοίνωσε σήμερα ότι η Ευρωπαϊκή Επιτροπή χορήγησε Άδεια Κυκλοφορίας στην axicabtagene ciloleucel ως...

Η Novartis ανακοίνωσε πρόσφατα τα αποτελέσματα 14 μηνών από την βασική κλινική μελέτη JULIET που καταδεικνύουν ότι είναι δυνατή...

Ιδιαίτερα αποτελεσματική αποδεικνύεται η ανοσοθεραπεία για την αντιμετώπιση των υποτροπών του λεμφώματος Χότζκιν, οι οποίες μπορεί να συμβούν ακόμα...

Η Novartis φθάνει σε ακόμη ένα κανονιστικό ορόσημο για το CTL019 (tisagenlecleucel) με την υποβολή της Αίτησης Άδειας Κυκλοφορίας...

Στις 18 Οκτωβρίου 2017, ο οργανισμός Food and Drug Administration (FDA) των ΗΠΑ γνωμοδότησε θετικά για τη χορήγηση axicabtagene...